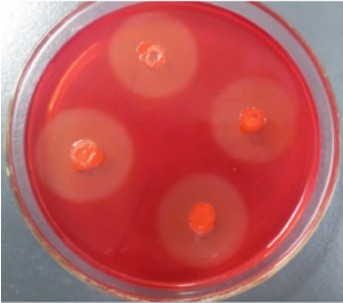
点击查看原图

2. 洛阳师范学院, 洛阳 471022
2. Luoyang Normal University, Luoyang 471022, China
藏香猪是在我国青藏高原高海拔地区的缺氧、寒冷、放牧条件下培育出的具有耐寒、抗病、食草、肉香、环保等优良特性的草食猪种,其在舍饲条件下仍可用90%的饲草来满足其营养需要[1]。因此,研究藏香猪的食草特性对于发展我国节粮型养猪业意义重大。目前,我国对藏香猪的研究主要集中在生长发育[2,3]、肉品质[4,5]及繁殖性状[6,7]等方面,对其高效利用粗纤维饲料这一优良特性的研究甚少。国内外大量研究表明,动物肠道的正常菌群与其营养及消化生理具有密切的关系,以草食为主的反刍动物,其瘤胃中50%纤维素的消化是由瘤胃细菌、真菌和原虫共同完成的,而在这一消化过程中80%由细菌完成[8,9]。此外,像大熊猫这种既有草食性哺乳动物的进食特点、又有肉食性消化系统的动物,对纤维素的消化也必须依赖其肠道特殊微生物的作用[10]。猪是杂食动物,胃的结构和机能属于肉食与草食复胃动物之间的过渡类型,同时具有发达的大肠。猪的消化腺虽然不能分泌纤维素酶,但在大肠纤维素分解菌的作用下,能分解纤维素作为能源供机体利用,而这种菌株主要存在盲肠[11]。藏香猪之所以能够将饲草作为主要营养来源,可能与其肠道内存在能够高效分解纤维素的纤维素分解菌有关。本试验拟采用羧甲基纤维素(CMC)平板法初筛和摇瓶发酵法复筛,从藏香猪盲肠内容物中分离和筛选能够高效分解纤维素的菌株,以揭示藏香猪能够高效利用粗纤维饲料的根源,为藏香猪食草机理的研究以及猪源益生菌株的开发利用提供菌种来源与研究基础。
试验样品于2012年9月采集于陕西华益实业有限公司藏香猪养殖基地的8月龄健康藏香猪。藏香猪的饲料主要为青草(90%),配以少量豆渣(10%)。屠宰后剖开腹腔,迅速分离盲肠,取20 cm左右的肠段,并在肠管两端用线绳结扎、剪断,装封口塑料袋中排气封口,放入冰盒迅速带回实验室,用于分离肠道细菌。
CMC筛选培养基[12,13]:CMC 10.0 g,蛋白胨 5.0 g,酵母粉0.5 g,磷酸氢二钾(K2HPO4) 1.5 g,七水合硫酸镁(MgSO4·7H2O) 0.2 g,氯化钠5.0 g,琼脂粉15.0 g,蒸馏水定容至1 000 mL。
LB液体培养基:胰蛋白胨提取物10.0 g,酵母提取物5.0 g,氯化钠10.0 g,蒸馏水定容至1 000 mL。
基础发酵培养基[14]:LB液体培养基中加入1.0%的CMC。
大肠杆菌感受态细胞DH5α、pGEM-T克隆载体均为本实验室保存,细菌基因组DNA试剂盒、小型质粒提取试剂盒、胶回收试剂盒、pGEM-T Easy载体购自北京天根生化科技有限公司,胰蛋白胨、酵母提取物、琼脂粉购自Oxoid公司,CMC购自Sigma公司,二喹啉甲酸(BCA)蛋白质浓度测定试剂盒购自北京索莱宝科技有限公司。其他化学试剂均为国产分析纯。
试验所用主要仪器有:PTC-1148型PCR仪、BG-gdsAUTO(510)型凝胶成像系统、ND-1000型紫外分光光度计、Beckman Coulter Allegra 64R台式高速冷冻离心机、DYY-6C型稳压稳流电泳仪等。
称取藏香猪盲肠内容物1.0 g,转移至盛有100 mL无菌水的三角瓶中,在80 ℃电热恒温振荡水浴锅中振荡30 min,即成10-2盲肠内容物稀释液,取适量梯度稀释为10-6~10-3样液。然后分别取100 μL稀释过的样液涂于相应稀释梯度编号的CMC平板上,CMC平板倒置于37 ℃恒温培养箱中培养24 h,采用刚果红染色法对菌株进行筛选[15]。根据菌落周围透明圈直径(D)与菌落直径(d)比值大小对活力强的菌株进行初步筛选。对D/d值大的菌落在CMC平板上反复划线分离纯化培养4~5代,并将纯化培养的菌种加甘油于-80 ℃保存备用。
将冷冻保存的D/d值大的菌种在LB平板上划线活化培养,用接种环挑取少量单菌落于LB液体培养基中,在37 ℃、220 r/min条件下摇菌培养12 h,然后再转接活化培养1~2次。最后以1.0%的接种量接种至LB液体培养基中摇菌培养12 h,制备成种子液。
将种子液以1.0%的接种量接种入50 mL基础发酵培养基内,在37 ℃、220 r/min条件下发酵培养24 h,于5 000 r/min、4 ℃条件下离心发酵液15 min,上清液即为粗酶液,对粗酶液进行适当稀释,用于羧甲基纤维素酶(CMCase)比活力的测定,最终以CMCase比活力高低作为筛选高产纤维素菌株的标准。
CMCase比活力的测定是通过测定还原糖的生成量来进行,葡萄糖标准曲线制作参考Miller[16]的方法进行。在试管中加入2.0 mL培养物的上清液和2.0 mL 1.0%羧甲基纤维素钠 (CMC-Na)溶液,在pH 5.5的0.1 mol/L醋酸缓冲液中,40 ℃水浴条件下准确反应30 min,加入5 mL 3,5-二硝基水杨酸溶液(DNS)终止反应,沸水煮沸5 min,冷却且用蒸馏水定容至25 mL后在540 nm处测吸光度(OD)值。粗酶液中每克酶蛋白所具有的酶活力定义为1个比活力,用U/g表示。
菌株形态学特征鉴定用革兰氏染色法[17]和孔雀石绿芽孢染色法[18],生理生化特性鉴定参考东秀珠等[19]和Garrity等[20]的方法进行。为进一步确认,提取菌株基因组DNA,采用细菌通用引物(27F:5′-AGAGTTTGATCCTGGCTCA-3′,1492R:5′-GGTTACCTTGTTACGACTT-3′)[21]对菌株的16S rRNA基因进行扩增。PCR纯化产物和pGEM-T进行T连接后转化大肠杆菌DH5α,测序由北京华大基因生物公司完成。将测序结果在NCBI上用BLAST程序与GenBank中16S rRNA基因序列进行同源性分析,用Mega 5.1中的邻接(neighbor-joining)法构建系统发育树。
将种子液以1.0%的接种量接入100 mL LB液体培养基,6 h后每间隔2 h取样1次,31 h后每隔4 h取样1次,直至60 h。测定时将培养液均稀释10倍,采用分光光度法测定600 nm处的OD值,绘制菌株生长曲线。此外,将种子液以1.0%接种量接种至基础发酵培养基,在37 ℃、220 r/min条件下发酵培养,研究选定纤维素分解菌不同发酵时间的产酶能力。
在需氧条件下,通过CMC平板法初筛,筛选出了10株透明圈明显的菌株,然后将初筛的菌株反复划线分离纯化培养4~5代,结合摇瓶发酵法复筛,最终确定选用发酵24 h时纤维素酶比活力最强的菌株C9(36.4 U/g)用于深入研究(表1)。将菌株C9点种于CMC平板上培养24 h,刚果红染色法染色后,菌落周围仍有很大的透明圈,说明该菌株具有强的分解CMC的能力,并且这种能力能够稳定遗传给后代(图 1)。
| 表1 纤维素分解菌的分离筛选 Table 1 Isolation and screening of cellulolytic bacterium |
| 图 1 菌株C9在CMC平板上的透明圈 Fig.1 Transparent circle of strain C9 on CMC plate |
经形态学研究发现,纤维素分解菌株C9菌落表面粗糙不透明,灰白色或微黄色,属于需氧菌;革兰氏染色阳性,显微镜下菌体呈杆状(图 2);用改良的孔雀石绿染色法进行芽孢染色后,芽孢被染成绿色,呈长椭圆状,位于菌体中央或稍偏,营养体呈红色(图 3)。
 | 图 2 菌株C9的革兰氏染色 Fig. 2 Gram staining of stain C9 (1 000×) |
 | 图 3 菌株C9的芽孢染色 Fig. 3 Spore staining of stain C9 (1 000×) |
根据菌株的形态学特征,从试验菌株的生理生化特性鉴定结果(表2)看,本试验中筛选到的菌株C9可初步鉴定为芽孢杆菌属的枯草芽孢杆菌(Bacillus subtilis)或其变种。
| 表2 菌株C9的生理生化特性鉴定结果 Table 2 Identification results of physiological and biochemical characteristics of strain C9 |
测序结果表明,菌株C9的16S rRNA基因序列长度为1 511 bp,其大小与预期结果相符(图 4)。在NCBI上用BLAST程序对菌株C9的16S rRNA基因测序结果(GenBank登录号:KC414931)进行同源性分析,结果表明,菌株C9与多株芽孢杆菌属的16S rRNA基因序列相似性达99%以上。从Mega 5.10构建的系统进化树(图 5)看, 该菌株与Bacillus subtilis subsp. subtilis strain DSM 10(GenBank登录号:NR_027552.1)亲缘关系最近。综合该菌株的形态学特征、生理生化特性鉴定结果,以及16S rRNA基因分子学鉴定结果,最终确定该菌株为Bacillus sublitis的一个亚种或变种,将其命名为Bacillus sublitis BY-2。该菌株目前已被中国典型培养物保藏中心(武汉大学保藏中心)保藏,保藏号为:CCTCCM 2012535。
 | 图 4 菌株C9 16S rRNA基因的PCR产物 Fig. 4 PCR products of 16S rRNA gene of strain C9 |
 | 图 5 菌株C9 16S rRNA基因序列的系统发育树 Fig. 5 Phylogenetic tree of 16S rRNA gene sequence of strain C9 |
从图6生长曲线看,Bacillus sublitis BY-2在接种后8~20 h为对数期,20 h以后进入稳定期,并且持续至40 h左右,40 h后菌体的繁殖逐渐进入衰退期。
 | 图6 Bacillus sublitis BY-2的生长曲线 Fig. 6 Growth curve of Bacillus sublitis BY-2 |
将种子液按1.0%接种量接种,在发酵的不同时间测定Bacillus sublitis BY-2所产CMCase的比活力。结果表明,在28 h内随着发酵时间的延长,Bacillus sublitis BY-2的产酶能力也逐渐增大,在发酵至28 h时CMCase的比活力达到最高(46.2 U/g),随后CMCase的比活力略有下降,但基本保持稳定(图 7)。
 | 图 7 Bacillus sublitis BY-2不同发酵时间的产酶能力 Fig. 7 Enzyme-producing ability of Bacillus sublitis BY-2 at different fermentation time /span> |
由图 8可知,Bacillus sublitis BY-2产CMCase 的最适反应pH为5.5。将Bacillus sublitis BY-2 的粗酶液与不同pH的缓冲液混匀,在40 ℃水浴保温1 h后,与最适反应pH相比,其所产CMCase的相对比活力在pH 3~8的范围内均在80%以上(图 9),说明Bacillus sublitis BY-2所产CMCase具有较强的耐酸碱性。
 | 图 8 pH对CMCase比活力的影响 Fig. 8 Effect of pH on CMCase specific activity |
 | 图 9 pH对CMCase稳定性的影响 Fig. 9 Effect of pH on CMCase stability |
在最适pH条件下,Bacillus sublitis BY-2产CMCase的最适反应温度为65 ℃(图 10);将Bacillus sublitis BY-2的粗酶液分别在不同温度下水浴保温1 h,其所产CMCase的比活力在50 ℃以上时迅速下降,在80 ℃时几乎失活(图 11)。
 | 图 10 温度对CMCase比活力的影响 Fig.10 Effect of temperature on CMCase specific activity |
 | 图 11 温度对CMCase稳定性的影响 Fig.11 Effect of temperature on CMCase stability |
此外,在最适反应pH及最适反应温度条件下,在反应5 min时CMCase比活力最高(138.1 U/g),随着与底物反应时间的延长,Bacillus sublitis BY-2所产CMCase的比活力逐渐降低,至30 min后CMCase比活力变化不大(图 12)。
 | 图 12 时间对CMCase比活力的影响 Fig.12 Effect of time on CMCase specific activity |
纤维素是植物通过光合作用生产的地球上最丰富、最廉价的可再生资源[25]。由于纤维素具有水不溶性的高结晶结构,其外围又被木质素层包围着,要把它水解成可利用的葡萄糖相当困难。此外,高成本的纤维素酶也是利用纤维素的障碍,因此,纤维素到目前为止仍没有得到很好地利用[26]。在畜牧业和饲料工业中,为了缓解目前能量饲料短缺的局面,高产纤维素分解菌种的分离筛选一直被人们重视。真菌所产的纤维素酶因种类齐全而被应用于食品、饲料、纺织、燃料和化学工业等生产领域中[27,28]。但真菌生长慢,生产纤维素酶成本高,因此,筛选具有培养简单、生长速度快、世代周期短等特点的纤维素分解菌具有较高的潜在应用性[29]。
以CMC为唯一碳源的选择培养基培养,用刚果红染色法来初步分离筛选纤维素分解菌,因简单快捷、成本低等优点,被广泛认为是初步筛选纤维素分解菌最好的方法[15]。目前,人们已从牛的瘤胃[30,31,32],犀牛[33]、藏香猪[24]以及大熊猫[12]的粪便,土壤[34],鹅的胃肠道[35]以及海洋细菌[36]等中分离出来了纤维素分解菌,主要有芽孢杆菌、梭菌、纤维菌属、瘤胃球菌属、拟杆菌属等[37,38]。
本试验将采集到的藏香猪盲肠内容物用蒸馏水适当稀释后,在80 ℃振荡水浴条件下振荡30 min,将不含芽孢的菌体及杂菌杀死,然后通过反复初筛和复筛,筛选出了1株能够高效分解纤维素的菌株Bacillus subtilis BY-2。该菌株在发酵培养至24 h时,其所产CMCase比活力高于Sadhu等[39,40]所报道的结果,但低于Wang等[41]所报道的真菌所产CMCase的比活力。
在微生物生长繁殖的过程中,种龄、种子液的浓度、接种量的大小、菌体培养条件以及培养基的营养成分等对其生长和代谢均有重要的影响[42]。本试验筛选的Bacillus subtilis BY-2菌株在接种8 h后生长开始进入对数期,20 h以后进入稳定期,并且持续至40 h左右,与汪海峰等[43]、高颖等[44]的试验结果基本一致,但却有别于殷晓敏等[45]的试验结果。从Bacillus subtilis BY-2在不同发酵时间的产酶能力看,其产酶特性与生长特性基本吻合,即:在8~20 h这一时期生长最快,为代谢旺盛、酶系活跃阶段;在20~40 h之间,进入稳定产酶阶段。在菌种选育过程中,生长速率快、产酶早、产酶量高的菌株常作为筛选的目标菌株,因为在微生物的工业生产中,菌体在单位时间内合成的目标产物的数量是生产成本的决定性因素[46]。另外,当产酶量高、生长速率快的菌株作为益生菌饲喂动物时,能够短时间在肠道内生长繁殖,维持肠道内微生态系统的稳衡[43]。
研究表明,在纤维素酶系中作用于底物的最适pH大多在4.0~5.5之间[47],虽然酶促反应pH较为集中,但又不统一,这可能与菌株来源等因素有关。本试验筛选出的Bacillus subtilis BY-2所产CMCase的最适反应pH为5.5,与Mawadza等[23]所报道的芽孢杆菌的试验结果基本一致,但低于Kim等[36]、刘海艳等[24]、Lee等[48]所报道的芽孢杆菌的试验结果,而高于Rawat等[49]、Rastogi等[50]所报道的芽孢杆菌的试验结果。此外,Bacillus subtilis BY-2所产CMCase在宽pH范围内具有较强的稳定性,这也是芽孢杆菌属细菌所产CMCase的共同特点[23]。
Bacillus subtilis BY-2产CMCase的最适反应温度为65 ℃,且在65~70 ℃范围内CMCase的比活力几乎维持在同一个水平,与Mawadza等[23]所报道的芽孢杆菌的试验基本一致,高于Lee等[48]和Kim等[36]、Rawat等[49]所报道的芽孢杆菌的试验结果,而低于Rastogi等[50]所报道的芽孢杆菌的试验结果。
Bacillus subtilis BY-2所产CMCase在最适反应pH和最适反应温度条件下,随着反应时间的延长,其比活力逐渐降低,30 min后曲线逐渐呈现水平状态。该试验结果与姜心等[51]的试验结果基本一致。这可能是因为随着反应的进行,底物浓度降低,产物浓度增加,逆反应从无到有,逐渐变得显著;同时,酸、热等因素也慢慢地使酶丧失部分活性。此外,酶反应的时间也与反应温度有关,反应时间延长,反应温度降低,反之则升高[52]。
① 根据菌株形态学特征、生理生化特性及16S rRNA分子鉴定,将从藏香猪盲肠内容物中分离出的纤维素分解菌命名为Baclitis sublitis BY-2。
② 酶学特性分析表明,Baclitis sublitis BY-2产CMCase的最适反应条件为:pH 5.5、65 ℃下反应5 min。
③ Baclitis sublitis BY-2生长速率快、产酶早、产酶能力强,且在pH 3~8的范围内具有较强的耐酸碱性,为细菌纤维素酶和微生态制剂的研发与生产提供了菌种来源与研究基础。
| [1] | 曹斌云.天然富氧运动的食草绿色养猪法的提出及意义——迎接第三次养猪业绿色革命浪潮的到来[J]. 北方牧业, 2010(19):12-13. ( 1) 1)
|
| [2] | 张浩, 强巴央宗, 王强, 等.藏猪体重非线性生长曲线分析[J]. 家畜生态学报, 2007, 28(6):41-43. ( 1) 1)
|
| [3] | 强巴央宗, 彭俊飞, 辜雪冬, 等.藏猪IGF Ⅰ基因外显子4和IGF Ⅱ基因内含子7 PCR-RFLP分析[J]. 西南农业学报, 2010, 23(3):912-915. ( 1) 1)
|
| [4] | 陈晓晖, 吕学斌, 何志平, 等.藏猪不同生长发育阶段胴体性能与肉质特性研究[J]. 西南农业报, 2009, 22(2):470-472. ( 1) 1)
|
| [5] | 宋社果, 安小鹏, 赵海波, 等.藏香猪屠宰特性及肉品质的分析[J]. 西北农业学报, 2011, 20(12):26-32. ( 1) 1)
|
| [6] | 张浩, 吴常信, 强巴央宗, 等.藏猪3个繁殖性状主效基因多态性研究[J]. 遗传, 2007, 29(8):939-944. ( 1) 1)
|
| [7] | 刘轩, 强巴央宗, 王强, 等.藏猪繁殖性状多基因效应分析[J]. 遗传, 2010, 32(5):480-485. ( 1) 1)
|
| [8] | CRAIG W M, BRODERICK G A, RICKER D B.Quantitation of microorganisms associated with the particulate phase of ruminal ingesta[J]. The Journal of Nutrition, 1987, 117(1):56-62. ( 1) 1)
|
| [9] | WHITE B A, MACKIE R I, DOERNER K C.Enzymatic hydrolysis of forage cell walls[M]//JUNG H G, BUXTON D R, HATFIELD R D, et al.Forage cell wall structure and digestibility.Madison:American Society of Agronomy, Inc., 1993:455-484. ( 1) 1)
|
| [10] | ZHU L, WU Q, DAI J, et al.Evidence of cellulose metabolism by the giant panda gut microbiome[J]. Proceedings of the National Academy of Sciences of the United States of America, 2011, 108(43):17714-17719. ( 1) 1)
|
| [11] | 任守让, 赵贵彬, 王瑞霞.猪盲肠内纤维素分解菌的分布[J]. 吉林农业科学, 1980(3):73-75. ( 1) 1)
|
| [12] | 樊程, 李双江, 李成磊, 等.大熊猫肠道纤维素分解菌的分离鉴定及产酶性质[J]. 微生物学报, 2012, 52(9):1113-1121. ( 2) 2)
|
| [13] | YANG D L, WENG H B, WANG M G, et al.Cloning and expression of a novel thermostable cellulase from newly isolated Bacillus subtilis strain I15[J]. Molecular Biology Reports, 2010, 37(4):1923-1929. ( 1) 1)
|
| [14] | BGUIN P.Detection of cellulase activity in polyacrylamide gels using Congo red-stained agar replicas[J]. Analytical Biochemistry, 1983, 131(2):333-336. ( 1) 1)
|
| [15] | TEATHER R M, WOOD P J.Use of Congo red polysaccharide interactions complex formation between Congo red and polysaccharide in detection and assay of polysaccharide hydrolases[J]. Methods Enzymol, 1982, 160:59-74. ( 2) 2)
|
| [16] | MILLER G L.Use of dinitrosalicylic acid reagent for determination of reducing sugar[J]. Analytical Chemistry, 1959, 31(3):426-428. ( 1) 1)
|
| [17] | 钱存柔, 黄仪秀.微生物学实验教程[M]. 北京:北京大学出版社, 1999. ( 2) 2)
|
| [18] | 朱陶, 付灿.几种芽孢染色方法的比较与改进[J]. 井冈山学院学报:自然科学版, 2008, 29(8):49-50. ( 1) 1)
|
| [19] | 东秀珠, 蔡妙英.常见细菌系统鉴定手册[M]. 北京:科学出版社, 2001. ( 1) 1)
|
| [20] | GARRITY G M, BELL J A, LILBURN T G.Taxonomic outline of the procaryotes, bergey's manual of systematic bacteriology[M]. 2nd ed.New York:Springer Press, 2004. ( 1) 1)
|
| [21] | SUZUKI M T, GIOVANNONI S J.Bias caused by template annealing in the amplification of mixtures of 16S rRNA genes by PCR[J]. Applied and Environmental Microbiology, 1996, 62(2):625-630. ( 1) 1)
|
| [22] | 李忠玲, 王卫卫, 任平, 等.产碱性纤维素酶兼性厌氧菌株的筛选和酶学性质的初步研究[J]. 微生物学通报, 2008, 35(6):851-854. ( 2) 2)
|
| [23] | MAWADZA C, HATTI-KAUL R, ZVAUYA R, et al.Purification and characterization of cellulases produced by two Bacillus strains[J]. Journal of Biotechnology, 2000, 83(3):177-187. ( 5) 5)
|
| [24] | 刘海艳, 白龙, 赵海波, 等.纤维素酶高产菌的筛选鉴定及纤维素酶基因的克隆与表达[J]. 中国农业大学学报, 2012, 17(5):92-98. ( 4) 4)
|
| [25] | WHITAKER J R.New and future uses of enzymes in food processing[J]. Food Biotechnology, 1990, 4(2):669-697. ( 1) 1)
|
| [26] | LYND L R, LASER M S, BRANSBY D, et al.How biotech can transform biofuels[J]. Nature Biotechnology, 2008, 26(2):169-172. ( 1) 1)
|
| [27] | SUKUMMARAN R K, SINGHANIA R R, PANDEY A.Microbial cellulases-production, applications and challenges[J]. Journal of Scientific and Industrial Research, 2005, 64(11):832-844. ( 1) 1)
|
| [28] | SINGHANIA R R, SUKUMARAN R K, PATEL A K, et al.Advancement and comparative profiles in the production technologies using solid-state and submerged fermentation for microbial cellulases[J]. Enzyme and Microbial Technology, 2010, 46(7):541-549. ( 1) 1)
|
| [29] | WESTERS L, WESTERS H, QUAX W J.Bacillus subtilis as cell factory for pharmaceutical proteins:a biotechnological approach to optimize the host organism[J]. Biochimica et Biophysica Acta:Molecular Cell Research, 2004, 1694(1/2/3):299-310. ( 1) 1)
|
| [30] | FORSBERG C W, BEVERIDGE T J, HELLSTROM A.Cellulase and xylanase release from Bacteroides succinogenes and its importance in the rumen environment[J]. Applied and Environmental Microbiology, 1981, 42(5):886-896. ( 1) 1)
|
| [31] | OHARA H, KARITA S, KIMURA T, et al.Characterization of the cellulolytic complex (cellulosome) from Ruminococcus albus[J]. Bioscience, Biotechnology, and Biochemistry, 2000, 64(2):254-260. ( 1) 1)
|
| [32] | AURILIA V, MARTIN J C, MCCRAE S I, et al.Three multidomain esterases from the cellulolytic rumen anaerobe Ruminococcus flavefaciens 17 that carry divergent dockerin sequences[J]. Microbiology, 2000, 146(6):1391-1397. ( 1) 1)
|
| [33] | SINGH S, MOHOLKAR V S, GOYAL A.Isolation, identification, and characterization of a cellulolytic Bacillus amyloliquefaciens strain SS35 from rhinoceros dung[J]. Microbiology, 2013(2013).http://dx.doi.org/10.1155/2013/728134. ( 1) 1)
|
| [34] | MONSERRATE E, LESCHINE S B, CANALE-PARLA E.Clostridium hungatei sp.nov., a mesophilic, N2-fixing cellulolytic bacterium isolated from soil[J]. International Journal of Systematic and Evolutionary Microbiology, 2001, 51(1):123-132. ( 1) 1)
|
| [35] | 高云航, 张喜宏, 刘佳丽, 等.鹅肠道纤维素分解菌的分离鉴定及其产酶条件的优化[J]. 动物营养学报, 2011, 23(3):466-472. ( 1) 1)
|
| [36] | KIM B K, LEE B H, LEE Y J, et al.Purification and characterization of carboxymethylcellulase isolated from a marine bacterium, Bacillus subtilis subsp. subtilis A-53[J]. Enzyme and Microbial Technology, 2009, 44(6):411-416. ( 3) 3)
|
| [37] | ROBSON L M, CHAMBLISS G H.Cellulases of bacterial origin[J]. Enzyme and Microbial Technology, 1989, 11(10):626-644. ( 1) 1)
|
| [38] | DOI R H.Cellulases of mesophilic microorganisms[J]. Annals of the New York Academy of Sciences, 2008, 1125(1):267-279. ( 1) 1)
|
| [39] | SADHU S, SAHA P, MAYILRAJ S, et al.Lactose-enhanced cellulase production by Microbacterium sp. isolated from fecal matter of zebra (Equus zebra)[J]. Current Microbiology, 2011, 62(3):1050-1055. ( 1) 1)
|
| [40] | SADHU S, GHOSH P K, DE T K, et al.Optimization of cultural condition and synergistic effect of lactose with carboxymethyl cellulose on cellulase production by Bacillus sp. isolated from fecal matter of elephant (Elephas maximus)[J]. Advances in Microbiology, 2013, 3(3):280-288. ( 1) 1)
|
| [41] | WANG X J, BAI J G, LIANG Y X.Optimization of multienzyme production by two mixed strains in solid-state fermentation[J]. Applied Microbiology and Biotechnology, 2006, 73(3):533-540. ( 1) 1)
|
| [42] | 周德庆.微生物学教程[M]. 2版.北京:高等教育出版社, 2002. ( 1) 1)
|
| [43] | 汪海峰, 王井亮, 王翀, 等.一株肠源枯草芽孢杆菌的生长、抗逆和产酶特性分析[J]. 中国畜牧杂志, 2012, 48(17):66-69. ( 2) 2)
|
| [44] | 高颖, 褚维伟, 张霞, 等.猪粪除臭微生物筛选及其生长曲线测定[J]. 山地农业生物学报, 2011, 30(1):47-51. ( 1) 1)
|
| [45] | 殷晓敏, 郑服从, 贺春萍, 等.枯草芽孢杆菌B215生物学特性及对香蕉枯萎病的生防效果评价[J]. 热带作物学报, 2010, 31(8):1416-1419. ( 1) 1)
|
| [46] | 何力.草鱼纤维素分解菌筛选、酶提纯及其相关活性研究[D]. 博士学位论文.武汉:华中农业大学, 2008. ( 1) 1)
|
| [47] | 张树政.酶制剂工业[M]. 北京:科学出版社, 1984:595-623. ( 1) 1)
|
| [48] | LEE Y J, KIM B K, LEE B H, et al.Purification and characterization of cellulase produced by Bacillus amyoliquefaciens DL-3 utilizing rice hull[J]. Bioresource Technology, 2008, 99(2):378-386. ( 2) 2)
|
| [49] | RAWAT R, TEWARI L.Purification and characterization of an acidothermophilic cellulase enzyme produced by Bacillus subtilis strain LFS3[J]. Extremophiles, 2012, 16(4):637-644. ( 2) 2)
|
| [50] | RASTOGI G, BHALLA A, ADHIKARI A, et al.Characterization of thermostable cellulases produced by Bacillus and Geobacillus strains[J]. Bioresource Technology, 2010, 101(22):8798-8806. ( 2) 2)
|
| [51] | 姜心, 陈伟, 周波, 等.纤维素酶活测定影响因素的研究[J]. 食品工业科技, 2010, 23(5):65-68. ( 1) 1)
|
| [52] | CHANG V S, HOLTZAPPLE M T.Fundamental factors affecting biomass enzymatic reactivity[J]. Applied Biochemistry and Biotechnology, 2000, 84/85/86(1/2/3/4/5/6/7/8/9):5-37. ( 1) 1)
|





